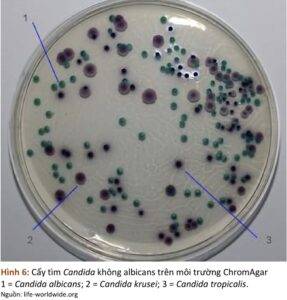
Screenshot 20260115 102005 ReadEra

III. Triệu chứng lâm sàng:
1. Ngứa:
– Ngứa âm hộ – âm đạo.
– Đôi khi có cảm giác nóng hoặc tiểu rát hoặc giao hợp đau.
– Âm hộ và niêm mạc âm đạo viêm đỏ.

2. Huyết trắng:
– Màu trắng đục.
– Vón cục, lợn cợn đóng thành mảng giống sữa đông.
– Bám thành âm đạo.

IV. Chẩn đoán cận lâm sàng:
1. pH âm đạo:
pH 4-4,5. [1]
2. Soi tươi huyết trắng:
– Soi dịch âm đạo được thực hiện bằng cách hòa bệnh phẩm lấy trên thành bên âm đạo với NaCl 0.9% và nhuộm màu với xanh methylene, sau đó quan sát dưới kính hiển vi. [2]
– Thấy có sợi tơ nấm hoặc bào tử nấm
– Dễ thấy hơn nếu nhỏ thêm 1 giọt KOH 10% vào bệnh phẩm
– Có thể âm tính đến 50% các trường hợp.

3. Cấy nấm:
– Cần thiết để chẩn đoán xác định, tránh điều trị quá mức trên những trường hợp có triệu chứng lâm sàng điển hình nhưng pH âm đạo bình thường và soi huyết trắng bình thường.
– Cho biết chủng của nấm, giúp lựa chọn đúng thuốc kháng nấm. [1]
– Hiếm khi phải dùng đến cấy nấm trên môi trường chuyên dụng. Cấy trên môi trường chuyên dụng được chỉ định trong những trường hợp thất bại với điều trị kháng nấm, nhằm định danh các chủng không phải là Candida albicans hoặc trong trường hợp VVC được xếp vào loại VVC có biến chứng (theo CDC). [2]
– Nên được thực hiện trên những bệnh nhân có triệu chứng dai dẳng hoặc tái phát vì có khả năng những bệnh nhân này nhiễm non-albicans kháng với azol. [1]
– Các xét nghiệm kết tụ latex (latex agglutination tests) có thể được dùng cho các trường hợp nhiễm chủng không Candida albicans, vì chúng không biểu hiện sợi tơ nấm giả trên mẫu thử. [2]
V. Chẩn đoán phân biệt:
Những trường hợp có triệu chứng nhưng pH âm đạo bình thường
– Phản ứng quá mẫn
– Dị ứng
– Viêm da do tiếp xúc.
VI. Viêm âm đạo do nấm tái phát:
– Nhiễm ≥ 4 lần/năm.
– 5 -8% phụ nữ.
– Do tái nhiễm từ một chủng nấm tồn tại trong âm đạo.
– Cấy nên được thực hiện để chẩn đoán xác định và để phát hiện những chủng nấm ít gặp.
– Chỉ một số ít trường hợp có yếu tố nguy cơ rõ như kiểm soát đường huyết kém, suy giảm miễn dịch.
– Đa số trường hợp có thể có liên quan với bất thường miễn địch niêm mạc âm đạo và yếu tố di truyền như kháng nguyên nhóm máu Lewis, gen đa hình đặc biệt.
– Viêm tái phát có liên quan với giảm nồng độ Manose Binding Lectin (MBL) và tăng nồng độ interleukin-4 (do biến thể của 2 gen đa hình đặc biệt).
+ Phản ứng trực tiếp của MBL với C. albicans giúp cơ thể kháng nấm, khi giảm MBL dễ nhiễm tái phát
+ Interleukin-4 ngăn đáp ứng kháng Candida thông qua đại thực bào, khi tăng IL-4 làm ngăn phản ứng đề kháng tại chỗ.
– Vấn đề lây truyền qua đường tình dục vẫn còn bàn cãi. Phần lớn nghiên cứu không ủng hộ việc điều trị cho bạn tình. Nghiên cứu 54 phụ nữ viêm tái phát, 1 bạn tình nam được điều trị ketoconazol, 200 mg/ngày trong 5 ngày, không khác biệt trong tỉ lệ tái phát của hai nhóm
– Nhiễm HIV [1]
Tài liệu tham khảo:
1. Ngô Thị Bình Lụa, Tô Mai Xuân Hồng, Viêm âm đạo do Candida sp.
Bệnh sinh, điểm mấu chốt của chẩn đoán, nguyên lý của điều trị, TBL Phụ Khoa, Nhà xuất bản y học, trang 58-61.
2. Bệnh viện Hùng Vương, Viêm âm đạo do nấm, Hướng dẫn điều trị Sản phụ khoa năm 2024, trang 52-60.
Tác giả: Lê Thị Thảo Hiền.
Hiệu đính: Nguyễn Hữu Tài, Phan Thị Nhật Nga.
Y khoa Diễn đàn Y khoa, y tế sức khoẻ, kiến thức lâm sàng, chẩn đoán và điều trị, phác đồ, diễn đàn y khoa, hệ sinh thái y khoa online, mới nhất và đáng tin cậy.
